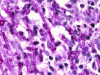

Infections caused by Scedosporium spp
- PMID: 18202441
- PMCID: PMC2223844
- DOI: 10.1128/CMR.00039-07
Infections caused by Scedosporium spp
Abstract
Scedosporium spp. are increasingly recognized as causes of resistant life-threatening infections in immunocompromised patients. Scedosporium spp. also cause a wide spectrum of conditions, including mycetoma, saprobic involvement and colonization of the airways, sinopulmonary infections, extrapulmonary localized infections, and disseminated infections. Invasive scedosporium infections are also associated with central nervous infection following near-drowning accidents. The most common sites of infection are the lungs, sinuses, bones, joints, eyes, and brain. Scedosporium apiospermum and Scedosporium prolificans are the two principal medically important species of this genus. Pseudallescheria boydii, the teleomorph of S. apiospermum, is recognized by the presence of cleistothecia. Recent advances in molecular taxonomy have advanced the understanding of the genus Scedosporium and have demonstrated a wider range of species than heretofore recognized. Studies of the pathogenesis of and immune response to Scedosporium spp. underscore the importance of innate host defenses in protection against these organisms. Microbiological diagnosis of Scedosporium spp. currently depends upon culture and morphological characterization. Molecular tools for clinical microbiological detection of Scedosporium spp. are currently investigational. Infections caused by S. apiospermum and P. boydii in patients and animals may respond to antifungal triazoles. By comparison, infections caused by S. prolificans seldom respond to medical therapy alone. Surgery and reversal of immunosuppression may be the only effective therapeutic options for infections caused by S. prolificans.
Figures

References
-
- Abzug, M. J., and T. J. Walsh. 2004. Interferon-gamma and colony-stimulating factors as adjuvant therapy for refractory fungal infections in children. Pediatr. Infect. Dis. J. 23:769-773. - PubMed
-
- Acharya, A., A. Ghimire, B. Khanal, S. Bhattacharya, N. Kumari, and R. Kanungo. 2006. Brain abscess due to Scedosporium apiospermum in a non immunocompromised child. Indian J. Med. Microbiol. 24:231-232. - PubMed
-
- Adelson, H. T., and J. A. Malcolm. 1968. Endocavitary treatment of pulmonary mycetomas. Am. Rev. Respir. Dis. 98:87-92. - PubMed
-
- Ahmed, A. O., W. van Leeuwen, A. Fahal, W. van de Sande, H. Verbrugh, and A. van Belkum. 2004. Mycetoma caused by Madurella mycetomatis: a neglected infectious burden. Lancet Infect. Dis. 4:566-574. - PubMed
Publication types
MeSH terms
Substances
LinkOut - more resources
Full Text Sources
Other Literature Sources
Miscellaneous

